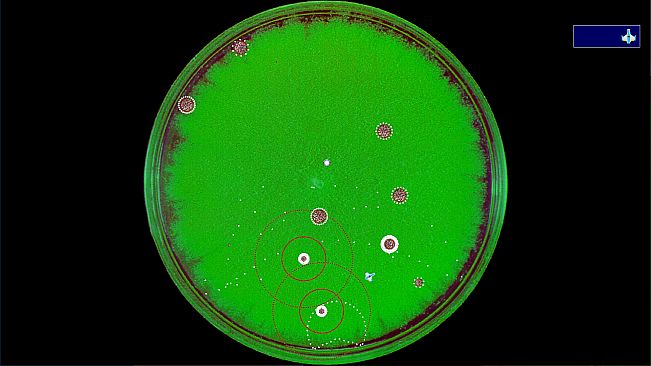
Coronavirus - Nano Force
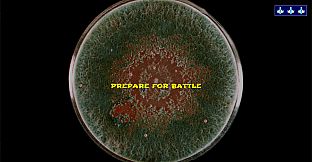
Coronavirus - Nano Force
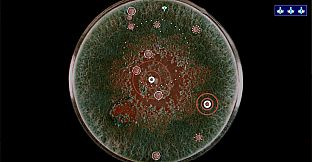
Coronavirus - Nano Force
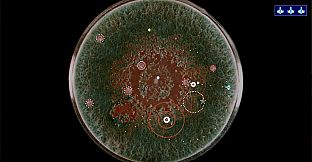
Coronavirus - Nano Force
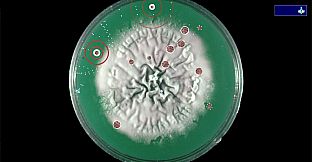
Coronavirus - Nano Force
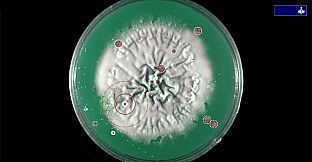
Coronavirus - Nano Force

Acheter Coronavirus - Nano Force PC Key
Coronavirus - Nano Force est gratuit sur Steam ! Également disponible dans 1 boutiques officielles dès 0,00 €.
À propos de Coronavirus - Nano Force
Train to become a pilot in the newly formed Nano Force. The Nano Force is being formed to aid in the fight against the Coronovius pandemic. Learn to become a nano-pilot so you can help humanity defeat the Coronavirus pandemic!
The game is composed of 5 Training levels and 3 Patient Simulations. The training levels familiarize you with the game, including how the environment works, piloting the ship, the weapons, and powerups. The Patient Simulation levels provide the opportunity to test your skill with increasingly difficult scenarios. The levels all take place in petri dishes, its just for fun.
Leaderboards are maintained for the fastest time to clear each of the Patient Simulation levels, along with Leaderboards for whoever can survive the longest and still clear the level. Challenge yourself by staying at the top of the leaderboards.
Play this game to release your pandemic tension by blasting away at the Coronavirus!
Minimum :
- Système d'exploitation: Windows 10
- Processeur: Any x64-based
- Graphismes: Any
- Stockage: 100 MB available space
Recommandé :
- Système d'exploitation: Windows 10
- Processeur: Any x64-based
- Graphismes: Any
- Stockage: 100 MB available space
Minimum :
- Système d'exploitation: Ubuntu 18
- Processeur: Any x64-based
- Graphismes: Any
- Stockage: 1 GB available space
Recommandé :
- Système d'exploitation: Ubuntu 18
- Processeur: Any x64-based
- Graphismes: Any
- Stockage: 1 GB available space
FAQ
8 questionsAvant de chercher une cle PC Coronavirus - Nano Force pas chère, verifiez l'essentiel. Développé par Daniel Snow. Publié par Daniel Snow. Date de sortie PC : 25 juin 2020. Genres : Action, Indie, Casual. Catégories : Single-player, Steam Achievements, Steam Leaderboards.
Où acheter une clé Steam ou CD Key Coronavirus - Nano Force pas chère ?
Coronavirus - Nano Force est gratuit ! Téléchargez-le sur Steam et commencez à jouer immédiatement.
Quel est le dernier prix Steam de Coronavirus - Nano Force ?
Coronavirus - Nano Force est entièrement gratuit sur Steam. Aucun achat nécessaire - il suffit de télécharger et de jouer. Si vous cherchez des DLC premium ou des objets en jeu, consultez le tableau des offres ci-dessus.
Promo et réduction Coronavirus - Nano Force PC - tout au même endroit
Notre traqueur de prix couvre les revendeurs officiels et les keyshops, vous pouvez donc trouver Coronavirus - Nano Force en promotion meme en dehors des périodes de soldes. Nous détectons actuellement 1 offre active provenant de boutiques officielles et de keyshops. Consultez le tableau ci-dessus, comparez avec le prix le plus bas historique et créez une alerte pour ne jamais manquer la prochaine baisse de prix.
Coronavirus - Nano Force est-il compatible avec GeForce NOW ?
D'apres nos données, Coronavirus - Nano Force n'est pas actuellement disponible sur GeForce NOW. Vous devrez le lancer localement sur votre PC. Parcourez les jeux disponibles sur GeForce NOW.
Puis-je acheter Coronavirus - Nano Force sur Steam ?
Oui. Coronavirus - Nano Force a une page officielle sur le Steam Store. Vous pouvez aussi acheter une cle Steam Coronavirus - Nano Force auprès de vendeurs tiers. Notre comparateur de prix inclut actuellement 1 offre avec DRM Steam. Choisissez-en une pour vous assurer que votre téléchargement de Coronavirus - Nano Force se fasse sur la plateforme de Valve.
Puis-je jouer à Coronavirus - Nano Force sur Steam Deck ?
Pas pour le moment. Valve classe Coronavirus - Nano Force comme non supporte sur Steam Deck. Gardez un oeil sur XD.deals - nous suivons les mises a jour Proton et les correctifs de la communaute. Parcourez les jeux Steam Deck Verified ou Steam Deck Playable.
Coronavirus - Nano Force est-il disponible sur PC Game Pass ou d'autres abonnéments ?
Coronavirus - Nano Force ne semble pas être disponible sur PC Game Pass, EA Play, Ubisoft+ ou tout autre service d'abonnément PC pour le moment. Votre seule option est d'acheter le jeu - utilisez XD.deals pour trouver le meilleur prix.
Puis-je acheter Coronavirus - Nano Force ici ?
Non - XD.deals n'est pas une boutique. Nous sommes un comparateur de prix qui suit les meilleures offres pour Coronavirus - Nano Force sur les boutiques officielles et les keyshops vérifiés. Cliquez sur "Voir l'offre" a cote de n'importe quelle offre et vous serez redirige vers le site du revendeur pour finaliser votre achat.
Meilleurs prix pour Coronavirus - Nano Force
Vous voulez acheter au meilleur moment ? Créez une alerte de prix sur XD.deals et soyez notifie quand Coronavirus - Nano Force atteint son prochain prix le plus bas historique.
Créer une alerte